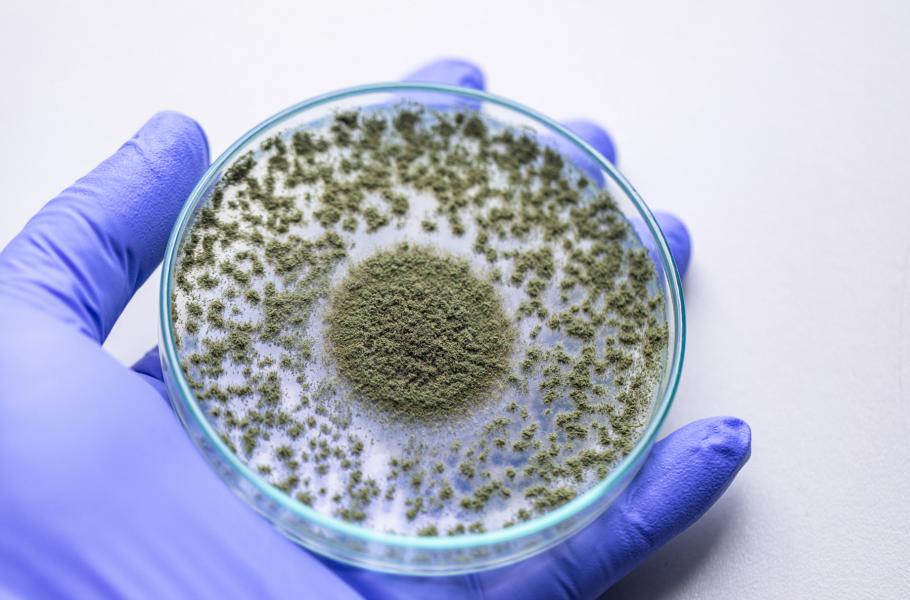

Plíseň jako lahůdka: Koji, miso pasta či omáčka garum v českých kuchyních
Fermentované potraviny se u Čechů těší stále větší oblibě, tudíž bylo jen otázkou času, kdy do našich kuchyní vtrhne i koji – klíčová ingredience japonské gastronomie. Řízené plesnivění surovin dnes navíc představuje natolik populární metodu, že s ní pracují už i špičkové restaurace
Žádná jiná houbovitá plíseň se nemůže pyšnit vlastními svátky ani tím, že lze díky ní okusit dnes již mezinárodně uznávanou pátou chuť umami. Řeč je o kropidláku rýžovém, který pomocí fermentace mění obyčejnou rýži, sóju či ječmen na tzv. koji, tedy hlavní součást sójových omáček, vína saké, rýžového octa či miso pasty. Pro Japonce jde nejen o základ domácí kuchyně, ale také o prvek národní kultury.
Střežené tajemství
Delikatese už přicházejí na chuť rovněž v gastronomických podnicích a do experimentování se již před více než rokem pustil i Erik Cehlár. Jelikož se ovšem v Japonsku považuje výroba koji za umění, a jeho příprava tak tvoří přísně střežené tajemství, nezbývá zástupci šéfkuchaře v karlínské restauraci Eska než postupovat metodou pokusu a omylu.
V pionýrských podmínkách vsadil na lokální suroviny a například rýži vyměnil za obyčejné kroupy. Uvařenou obilovinu přidá k plísňovému základu, osolí a nechá fermentovat. Výsledkem je miso pasta, jež slouží jako univerzální dochucovadlo: Nahradí kupovaný bujon, nemluvě o již zmiňovaném, naprosto neotřelém chuťovém zážitku umami.
Udělej si sám
Nejde o jediné kouzlo, které kropidlák dokáže. Smícháme-li ho s masem či kostmi a solí, načež vše zalijeme vodou a dáme minimálně na tři měsíce fermentovat při šedesáti stupních, vznikne garum – omáčka, jež v řadě ohledů svůj sójový protějšek předčí. Její hlavní benefit spočívá vedle unikátní chuti v tom, že ji lze připravit doma, a to takřka ze všech masných zbytků. Například Erik Cehlár používá kapří kosti či hovězí odřezky.
„Hovězí garum se hodně podobá masovému bujonu, ale neobsahuje žádná chemická aditiva. Rybí garum bych pro změnu přirovnal k asijské rybí omáčce, je však daleko jemnější, ne tak agresivní,“ popisuje Jiří Horák, kreativní šéfkuchař sítě restaurací. Garum může posloužit k dochucení masa, polévek i omáček. Nabízí velmi koncentrovanou chuť a navzdory obavám laiků nijak nezapáchá. „První reakce bývá spíš negativní. Lidé se bojí, že bude omáčka smrdět, ale opak je pravdou,“ dodává Cehlár.